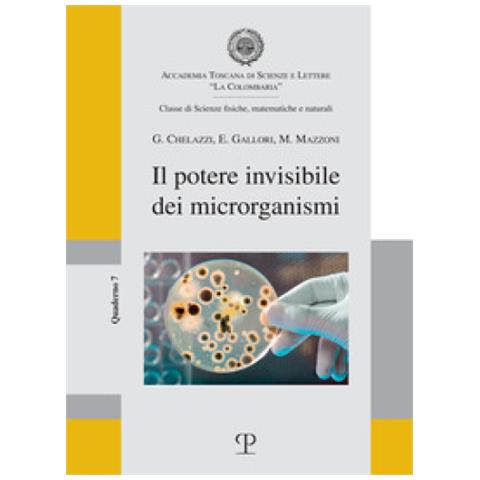
Guido Chelazzi - Il potere invisibile dei microrganismi - Foto 1

POLISTAMPA Guido Chelazzi - Il potere invisibile dei microrganismi
Pochi pezzi - Fino ad esaurimento scorte
Pochi pezzi - Fino ad esaurimento scorte
€ 12,99
AGGIUNGI AL CARRELLO
Venduto e spedito da ePRICE

- Informazioni legali
- Ne hai uno da vendere?
- 9788859622468
- 304906314
Sicurezza per i prodotti destinati ai consumatori
Immagini sulla sicurezza
Produttore
Responsabile all'interno dell'UE
Descrizione
Qualunque aspetto della vita sulla terra è influenzato dalle attività di organismi non visibili ad occhio nudo: batteri, virus, funghi. I microrganismi contribuiscono in modo fondamentale al funzionamento degli ecosistemi terrestri e oceanici e garan...
Scopri di piùCaratteristiche e scheda tecnica
Caratteristiche principali
- AutoreGuido Chelazzi - Enzo Gallori - Massimo Mazzoni
- Anno pubblicazione2022
- Pagine88
- EAN9788859622468
2026-04-28T14:28:32.000Z | 8ca3c59